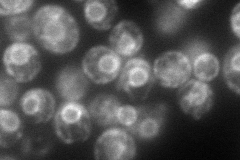
YEL031W
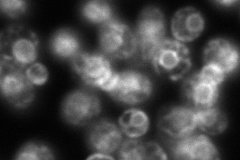
YEL031W
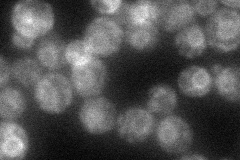
YEL031W
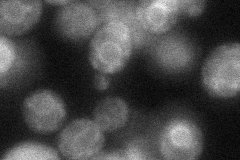
YEL031W
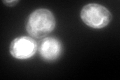
YEL031W

View description
P-type ATPase, ion transporter of the ER membrane involved in ER function and Ca2+ homeostasis; required for regulating Hmg2p degradation; confers sensitivity to a killer toxin (SMKT) produced by Pichia farinosa KK1
Localization:
Intensity:
Fold change:
Significance:
-
C’ GFP library in SD

ER112.44 -
N' NOP1pr-GFP in SD
ER133.934 -
N' TEF2pr-mCherry in SD
ER188.424 -
N' NATIVEpr-GFP in SD
ER52.3838 -
N' TEF2pr-VC and Cyto-VN in SD
ER46.0086 -
C’ GFP library in SD+DTT
ER174.971.55Yes -
C’ GFP library in SD+H2O2

ER111.80.99No -
C’ GFP library in Starvation Media

ER62.10.55Yes -
C’ GFP library on the background of Pup2-DaMP

ER -
C’ GFP library on the background of CCT mutant

ER77.45250.6888No
